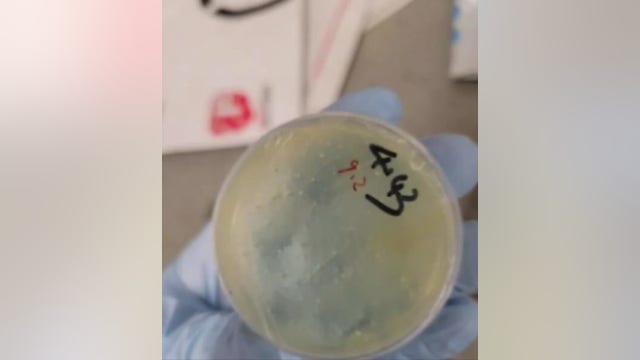
Second Chinese National charged with smuggling biological materials into US at Metro Airport

Men charged in connection with plan to open fire at Pontiac graduation appear in court
Both defendants were given high cash bonds as prosecutors argued they were threats to the public. According to attorneys, 20-year-old Jamarion Hardiman has "demonstrated he cannot and will not abide by any condition" from the court.
Both defendants were given high cash bonds as prosecutors argued they were threats to the public. According to attorneys, 20-year-old Jamarion Hardiman has "demonstrated he cannot and will not abide by any condition" from the court.
Second Chinese National charged with smuggling biological materials into US at Metro Airport
Customs and Border Protection officers conducted an inspection of Han, during which she made false statements about the packages and the biological materials she had previously shipped to the US.
Customs and Border Protection officers conducted an inspection of Han, during which she made false statements about the packages and the biological materials she had previously shipped to the US.
North Texas man charged with capital murder in girlfriend's forced abortion case
A North Texas man who works for the U.S. Department of Justice has been arrested and charged with capital murder after authorities said he secretly gave his pregnant girlfriend an abortion-inducing drug, causing the death of her six-week-old fetus.
A North Texas man who works for the U.S. Department of Justice has been arrested and charged with capital murder after authorities said he secretly gave his pregnant girlfriend an abortion-inducing drug, causing the death of her six-week-old fetus.
Child's quick thinking foils Tennessee home burglary, leads to fast arrest
A young child in Tennessee helped stop a home burglary by spotting an intruder rummaging through kitchen cabinets and quickly running to safety.
A young child in Tennessee helped stop a home burglary by spotting an intruder rummaging through kitchen cabinets and quickly running to safety.
Manhunt underway after deadly shooting on Las Vegas strip near tourist hotspot
Wild video shows terrified tourists dropping to the ground amid reports of gunfire in popular tourist area.
Wild video shows terrified tourists dropping to the ground amid reports of gunfire in popular tourist area.
Alcohol suspected in Michigan crash that killed woman
Police believe a driver was intoxicated when he crashed a vehicle in Tuscola County over the weekend, killing his passenger.
Police believe a driver was intoxicated when he crashed a vehicle in Tuscola County over the weekend, killing his passenger.
20-year-old driver in fatal I-94 hit-and-run says he didn't stop because he had been drinking
A driver in a hit-and-run crash that killed a man last month said he didn't stop because he had been drinking underage before striking the victim on I-94 in Ypsilanti Township.
A driver in a hit-and-run crash that killed a man last month said he didn't stop because he had been drinking underage before striking the victim on I-94 in Ypsilanti Township.
Man locked up for Detroit carjacking freed after another person confesses to crime
A man who spent years in prison for a Detroit carjacking was freed last month after a convicted murderer admitted to the crime.
A man who spent years in prison for a Detroit carjacking was freed last month after a convicted murderer admitted to the crime.
2 face weapons charges after alleged Pontiac graduation mass shooting attempt thwarted
Two men accused of planning to carry out a mass shooting at a Pontiac high school graduation ceremony last week are now facing weapons charges.
Two men accused of planning to carry out a mass shooting at a Pontiac high school graduation ceremony last week are now facing weapons charges.
Driver survives after flipping vehicle in west Michigan; alcohol suspected
Authorities believe a driver was intoxicated when they flipped their vehicle Friday night in west Michigan.
Authorities believe a driver was intoxicated when they flipped their vehicle Friday night in west Michigan.
Missouri man crashes into Michigan State Police vehicle while under influence of drugs
Police say a man from Missouri was under the influence of drugs when he crashed into a Michigan State Police vehicle during a traffic stop on I-94.
Police say a man from Missouri was under the influence of drugs when he crashed into a Michigan State Police vehicle during a traffic stop on I-94.
Natalee Holloway: 20 years since disappearance, Joran van der Sloot’s arrest
Natalee Holloway, an 18-year-old from Alabama, disappeared during a high school graduation trip to Aruba in May 2005.
Natalee Holloway, an 18-year-old from Alabama, disappeared during a high school graduation trip to Aruba in May 2005.
Live updates: Los Angeles protests escalate after National Guard deployed
Protests against immigration raids in Los Angeles turned destructive and violent Sunday: Officers were injured, vehicles were set on fire, and protesters blocked freeways.
Protests against immigration raids in Los Angeles turned destructive and violent Sunday: Officers were injured, vehicles were set on fire, and protesters blocked freeways.
Skydiving plane crashes in Tennessee with 20 people on board
A skydiving plane carrying 20 people crashed soon after taking off in Tennessee Sunday.
A skydiving plane carrying 20 people crashed soon after taking off in Tennessee Sunday.
Wayne County deputy dies in crash on Lodge freeway
When emergency vehicles arrived, the SUV was on fire and blocking more than one lane of traffic.
When emergency vehicles arrived, the SUV was on fire and blocking more than one lane of traffic.
Insurrection Act not off the table for LA protests, Trump says
President Donald Trump said he won’t rule out invoking the Insurrection Act as protests against immigration officers continue in Los Angeles for a third day.
President Donald Trump said he won’t rule out invoking the Insurrection Act as protests against immigration officers continue in Los Angeles for a third day.
Two killed in shooting on Detroit's west side, suspect in custody
The shooting happened around 2:40 a.m. in the 18900 block of Greydale Ave, near 7 Mile and Lahser.
The shooting happened around 2:40 a.m. in the 18900 block of Greydale Ave, near 7 Mile and Lahser.
Grandmother of suspect in school graduation shooting plot: 'I think it's crazy'
Lavonda Newburn finds it hard to believe her grandson, 20-year-old Jamarion Hardiman would be wanted for allegedly planning a mass shooting at a Pontiac high school graduation.
Lavonda Newburn finds it hard to believe her grandson, 20-year-old Jamarion Hardiman would be wanted for allegedly planning a mass shooting at a Pontiac high school graduation.
Royal Oak woman charged with fatally slashing her mother's throat
Police responding to an emergency call from a mother saying her daughter was having a mental health crisis made a startling discovery, finding the 66-year-old fatally wounded.
Police responding to an emergency call from a mother saying her daughter was having a mental health crisis made a startling discovery, finding the 66-year-old fatally wounded.
FBI Director Kash Patel says his home was targeted in swatting attempt
The FBI director broke the news about his home getting swatted during an interview with Joe Rogan.
The FBI director broke the news about his home getting swatted during an interview with Joe Rogan.